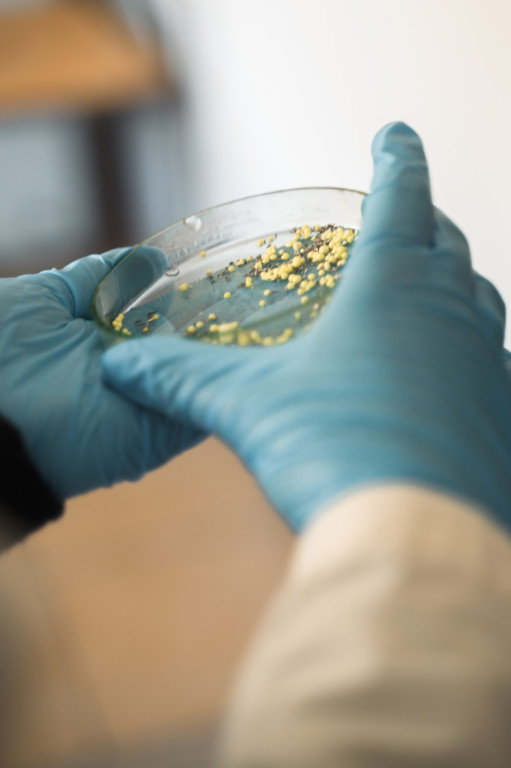

Dzień otwarty w ZSZ im. S. Petöfi w Ostródzie
Trwa akcja promocyjna wśród uczniów szkół podstawowych! Jedną z nich był Dzień Otwarty w ZSZ im. S. Petöfi w Ostródzie, który odbył się 20 maja. Zobaczcie poniżej zdjęcia z wydarzenia.
2025-05-22 10:22:06
Bus z dziećmi potrącił kobietę na chodniku
Przejdź do następnej fotorelacji